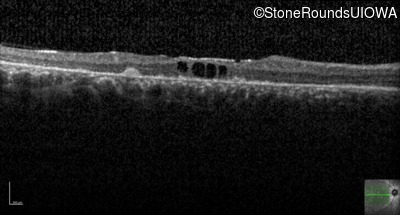
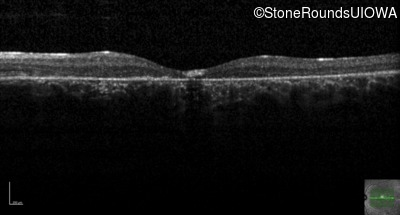

Case
SR437
Student Mode
AR Stargardt Disease (IIA)
Male
Male
Hidden
SR437
Student Mode
AR Stargardt Disease (IIA)
Male
Male
History
This 32 year old man first noticed difficulty reading road signs when he was 21 years old.
Diagnosis & molecular findings
| Disease | Gene | Allele 1 variant(s) | Allele 2 variant(s) | Inheritance mode |
|---|---|---|---|---|
| AR Stargardt Disease | ABCA4 | Arg681Stop CGA>TGA | Arg1860Trp CGG>TGG | AR |
Disease:
Gene:
Allele 1:
Arg681Stop CGA>TGA
Allele 2:
Arg1860Trp CGG>TGG
Inheritance:
AR